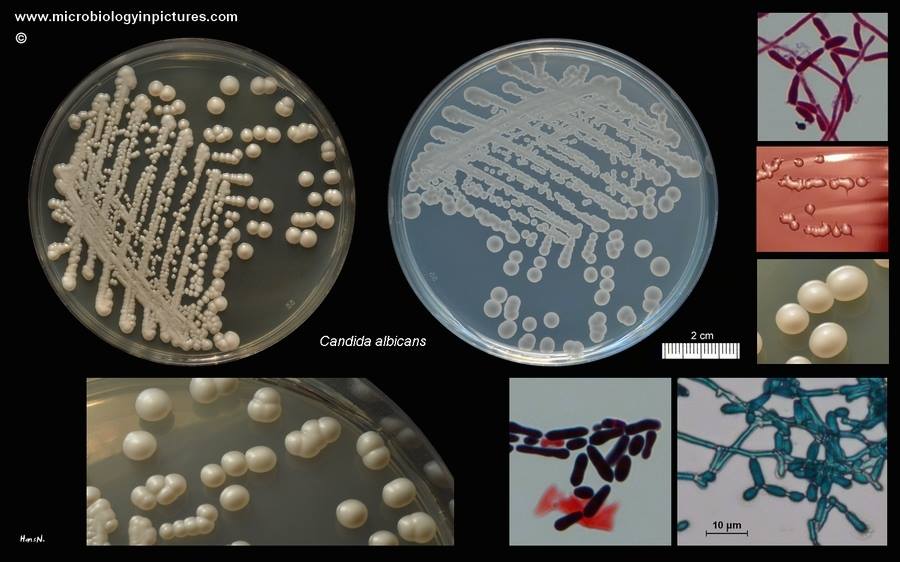

Drożdżak Candida np. Candida albicans , kiedy żyje w jelicie stanie równowagi z innymi bakteriami – nie czyni szkody. Jeśli jednak przyjazna flora bakteryjna zostanie naruszona np. poprzez antybiotyki, alkohol, zbyt duże spożycie cukru to szczepy Candida zajmują jej miejsce. Charakterystycznym etapem w procesie ekspansji grzybów Candida jest drożdżyca jelita grubego przyczyniająca się do pokonania bariery ochronnej organizm jaką jest błona śluzowa przewodu pokarmowego, co umożliwia drożdżakom Candida wniknięcie do krwiobiegu i zakażenie całego ustroju, zapoczątkowując proces zagrzybiania, zwany grzybicą ogólnoustrojową.Wystąpienie objawów grzybicy w jakimkolwiek miejscu organizmu należy uznać za objaw grzybicy ogólnoustrojowej. Zatem miejscowe leczenie objawów grzybicy – bez usunięcia grzybicy ogólnoustrojowej – jest pozbawione sensu.
OBJAWY ZAKAŻEŃ DROŻDŻAKAMI:
senność
problemy skórne
stany depresyjne
apatia wypryski
stan przemęczenia
dekoncentracja
wypadanie włosów
migreny
silne zaburzenia emocjonalne
łaknienie na słodycze
agresja
Ogólnie Candida będzie wskazywała na kiepski stan naszych jelit, spadek odporności i osłabienie organizmu.
BADANIA
Jedyną referencyjną metodą sprawdzenia ilości Candidy w przewodzie pokarmowym jest ilościowe badanie kału. Tylko dzięki temu badaniu dowiadujemy się dokładnie, ile konkretnego gatunku grzyba znajduje się w przewodzie pokarmowym. Jest to istotna informacja, gdyż możemy ocenić dzięki temu czy dana ilość znajduje się w ilościach referencyjnych, czy może mamy do czynienia z patologicznym rozlepem grzybów w jelitach.
Źródło: dr n. med Mirosława Gałęcka, Jak diagnozować grzyby Candida albicans, Hipoalergiczni.pl, Grudzień, 7, 2016
LECZENIE
Leczenie nadmiernego rozrostu candidy opiera się na czterech filarach:
a) wybijaniu kolonii candidy środkami naturalnymi i/lub farmakologicznymi
b) kolonizowaniu jelit bakteriami lacidofilnymi
c) odbudowywaniu odporności
d) wspieraniu powyższych działań dietą
DIETA
Walkę z omawianym patogenem możemy rozpocząć poprzez zmianę sposobu żywienia i stosowanie naturalnych preparatów przeciwgrzybicznych: Candida Clear, wyciąg z orzecha czarnego, Koci Pazur, olejek z oregano, olej z czarnuszki egipskiej czy pektyny grejfruta. Należy wykluczyć pokarmy, stymulujące rozwój grzybów: cukier, słodycze, wszelkie uniwersalne tłuszcze rafinowane, żywność wysoko przetworzoną, a także produkty wytwarzane na bazie białej mąki. Ograniczyć trzeba ziemniaki, słodkie owoce, nabiał, mięso, produkty mogące zawierać metale ciężkie- ryby morskie, jak również alkohol, kofeinę, musztardę czy ocet. W leczeniu pomocne są probiotyki, olej lniany, przyprawy, zioła, świeże warzywa, czosnek. Należy jeść jak najbardziej urozmaicenie i rotować pokarmy (nie jeść tego samego np. 3 czy 4 dni pod rząd, żeby uniknąć ryzyka wytworzenia się reakcji alergicznej), jeść często i w niewielkich ilościach. Powinnyśmy pić 2 litry wody dziennie, które pomogą wypłukać mykotoksyny z naszego organizmu. Oprócz wody warto włączyć do menu świeży sok z grejpfruta lub herbatę zieloną. Rano warto sięgnąć po szklankę ciepłej wody z cytryną. Antybakteryjne właściwości cytryny blokują rozmnażanie się Candidy. Ponadto taki ciepły napój z rana pobudza system trawienny
Zaznaczyć należy, że nie ma jednej uniwersalnej diety przy kandydozie. Często występują tu nietolerancje pokarmowe, stąd to, co jednemu służy, może zaszkodzić drugiemu.
WIĘCEJ INFORMACJI TUTAJ